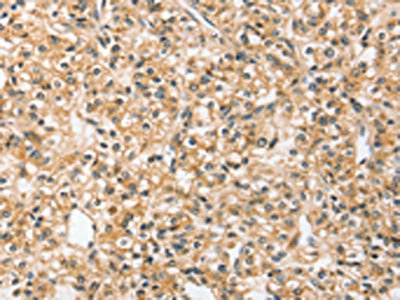

SLC44A2 Antibody
-
中文名稱:SLC44A2兔多克隆抗體
-
貨號:CSB-PA190316
-
規格:¥1100
-
圖片:
-
The image on the left is immunohistochemistry of paraffin-embedded Human prostate cancer tissue using CSB-PA190316(SLC44A2 Antibody) at dilution 1/20, on the right is treated with synthetic peptide. (Original magnification: ×200)
-
The image on the left is immunohistochemistry of paraffin-embedded Human liver cancer tissue using CSB-PA190316(SLC44A2 Antibody) at dilution 1/20, on the right is treated with synthetic peptide. (Original magnification: ×200)
-
-
其他:
產品詳情
-
Uniprot No.:
-
基因名:
-
別名:Choline transporter like protein 2 antibody; Choline transporter-like protein 2 antibody; CTL 2 antibody; CTL2 antibody; CTL2_HUMAN antibody; DKFZp666A071 antibody; FLJ44586 antibody; PP1292 antibody; SLC44A2 antibody; Solute carrier family 44 (choline transporter) member 2 antibody; Solute carrier family 44 member 2 antibody; Testicular tissue protein Li 47 antibody
-
宿主:Rabbit
-
反應種屬:Human
-
免疫原:Synthetic peptide of Human SLC44A2
-
免疫原種屬:Homo sapiens (Human)
-
標記方式:Non-conjugated
-
抗體亞型:IgG
-
純化方式:Antigen affinity purification
-
濃度:It differs from different batches. Please contact us to confirm it.
-
保存緩沖液:-20°C, pH7.4 PBS, 0.05% NaN3, 40% Glycerol
-
產品提供形式:Liquid
-
應用范圍:ELISA,IHC
-
推薦稀釋比:
Application Recommended Dilution ELISA 1:1000-1:2000 IHC 1:25-1:100 -
Protocols:
-
儲存條件:Upon receipt, store at -20°C or -80°C. Avoid repeated freeze.
-
貨期:Basically, we can dispatch the products out in 1-3 working days after receiving your orders. Delivery time maybe differs from different purchasing way or location, please kindly consult your local distributors for specific delivery time.
-
用途:For Research Use Only. Not for use in diagnostic or therapeutic procedures.
相關產品
靶點詳情
-
功能:Isoform 1, but not isoform 3, exhibits some choline transporter activity.
-
基因功能參考文獻:
- Variants in SLC44A2 gene is associated with thrombosis. PMID: 26908601
- SLC44A2 SNPs are associated with Meniere's disease severity. PMID: 27829169
- Although circulating nucleosomes and elastase - alpha 1-antitrypsin complexes are at present the best characterized biomarkers for neutrophil extracellular traps formation and neutrophil activation, their lack of association with rs2288904 genotype does not exclude a role for SLC44A2 in neutrophil activation (and possibly NET formation) in Venous Thromboembolism. PMID: 27093231
- The differential expression pattern of CTL1 and CTL2 suggests that CTL1 is the key transporter involved in choline transport from maternal circulation and both transporters are likely involved in stromal and endothelial cell choline transport. PMID: 26601765
- The Yi population of China had the highest frequency of blood donors at risk of harboring anti-HNA-3a compared to any population PMID: 26593331
- Study found 38 SNPs, including one novel SNP, in 8192 nucleotides covering the CDS of the SLC44A2 gene among 302 blood donors. PMID: 26437811
- The HNA-3 incompatibility in central Thais (33.28%) was higher than northern Thais (28.75%), corresponding to a significantly higher probability of HNA-3a alloimmunization (P<0.05) similar to Japanese and Chinese populations. This study showed the high risk of HNA-3 incompatibility and alloimmunization, especially in central Thai blood donors. PMID: 25608003
- HNA-3a (CTL2) antibodies in the pathogenesis of transfusion-related acute lung injury PMID: 25006121
- Meta-analysis of 65,734 individuals identifies TSPAN15 and SLC44A2 as two susceptibility loci for venous thromboembolism. PMID: 25772935
- The findings show that, for binding to CTL2, Type 2 HNA-3a antibodies require nonpolymorphic amino acid residues in the third, and possibly the second, EC loops of CTL2 PMID: 24846273
- Allele frequencies were determined in the blood donor population as follows: 0.318 for HNA-1a, 0.668 for HNA-1b, 0.014 for HNA-1c, 0.768 for HNA-3a, 0.232 for HNA-3b, 0.882 for HNA-4a, 0.118 for HNA-4b, 0.736 for HNA-5a and 0.264 for HNA-5b. PMID: 23398146
- inherited 537T variant of CTL2 gene is located in HNA-3a allele results impaired granulocyte agglutination by four of 14 antibodies tested while 988T remains nearly unaffected. PMID: 21564101
- HNA-3b/b genotype results for six different racial and ethnic groups showed that there could be a significant risk of producing anti-HNA-3a in Chinese, and Caucasian and Asian Indian blood donors, but low risk in Hispanic, African, or Native Americans. PMID: 22414054
- HEK293 cells expressing full-length CTL2 proteins were useful in the detection of HNA-3 antibodies even in the presence of HLA antibodies. PMID: 22211383
- African Americans have a significantly lower probability of possessing the SLC44A2*2 allele and may thus be less likely to form the clinically relevant anti-HNA-3a. PMID: 22040064
- SLC44A2 P1 and P2 isoforms with differing glycosylation are variably expressed in cochlea, tongue, heart, colon, lung, kidney, liver and spleen suggesting tissue specific differences that may influence function in each tissue. PMID: 20665236
- In conclusion, choline transport in A549 cells is increased by treatment with DEX, and the increase is mediated by induction of functional choline transporters CTL1 and CTL2. PMID: 20410607
- Mass spectrometric analysis of proteins immunoprecipitated from leukocytes by anti-HNA-3a provided direct evidence that anti-HNA-3a recognizes choline transporter-like protein 2. PMID: 20040764
- SNP with arginine rather than glutamine at position 154 constitutes HNA-3a antigen and risk of transfusion-related acute lung injury (TRALI) PMID: 20037594
- CTL2 is more widely distributed than previously described, and its prominent expression on cells facing the scala media suggests a possible role in homeostasis. PMID: 17926100
顯示更多
收起更多
-
亞細胞定位:Membrane; Multi-pass membrane protein.
-
蛋白家族:CTL (choline transporter-like) family
-
組織特異性:Present in supporting cells of the inner ear (at protein level). Only isoform 3 is expressed in inner ear vestibular tissue.
-
數據庫鏈接:
Most popular with customers
-
YWHAB Recombinant Monoclonal Antibody
Applications: ELISA, WB, IHC, IF, FC
Species Reactivity: Human, Mouse, Rat
-
Phospho-YAP1 (S127) Recombinant Monoclonal Antibody
Applications: ELISA, WB, IHC
Species Reactivity: Human
-
-
-
-
-
-